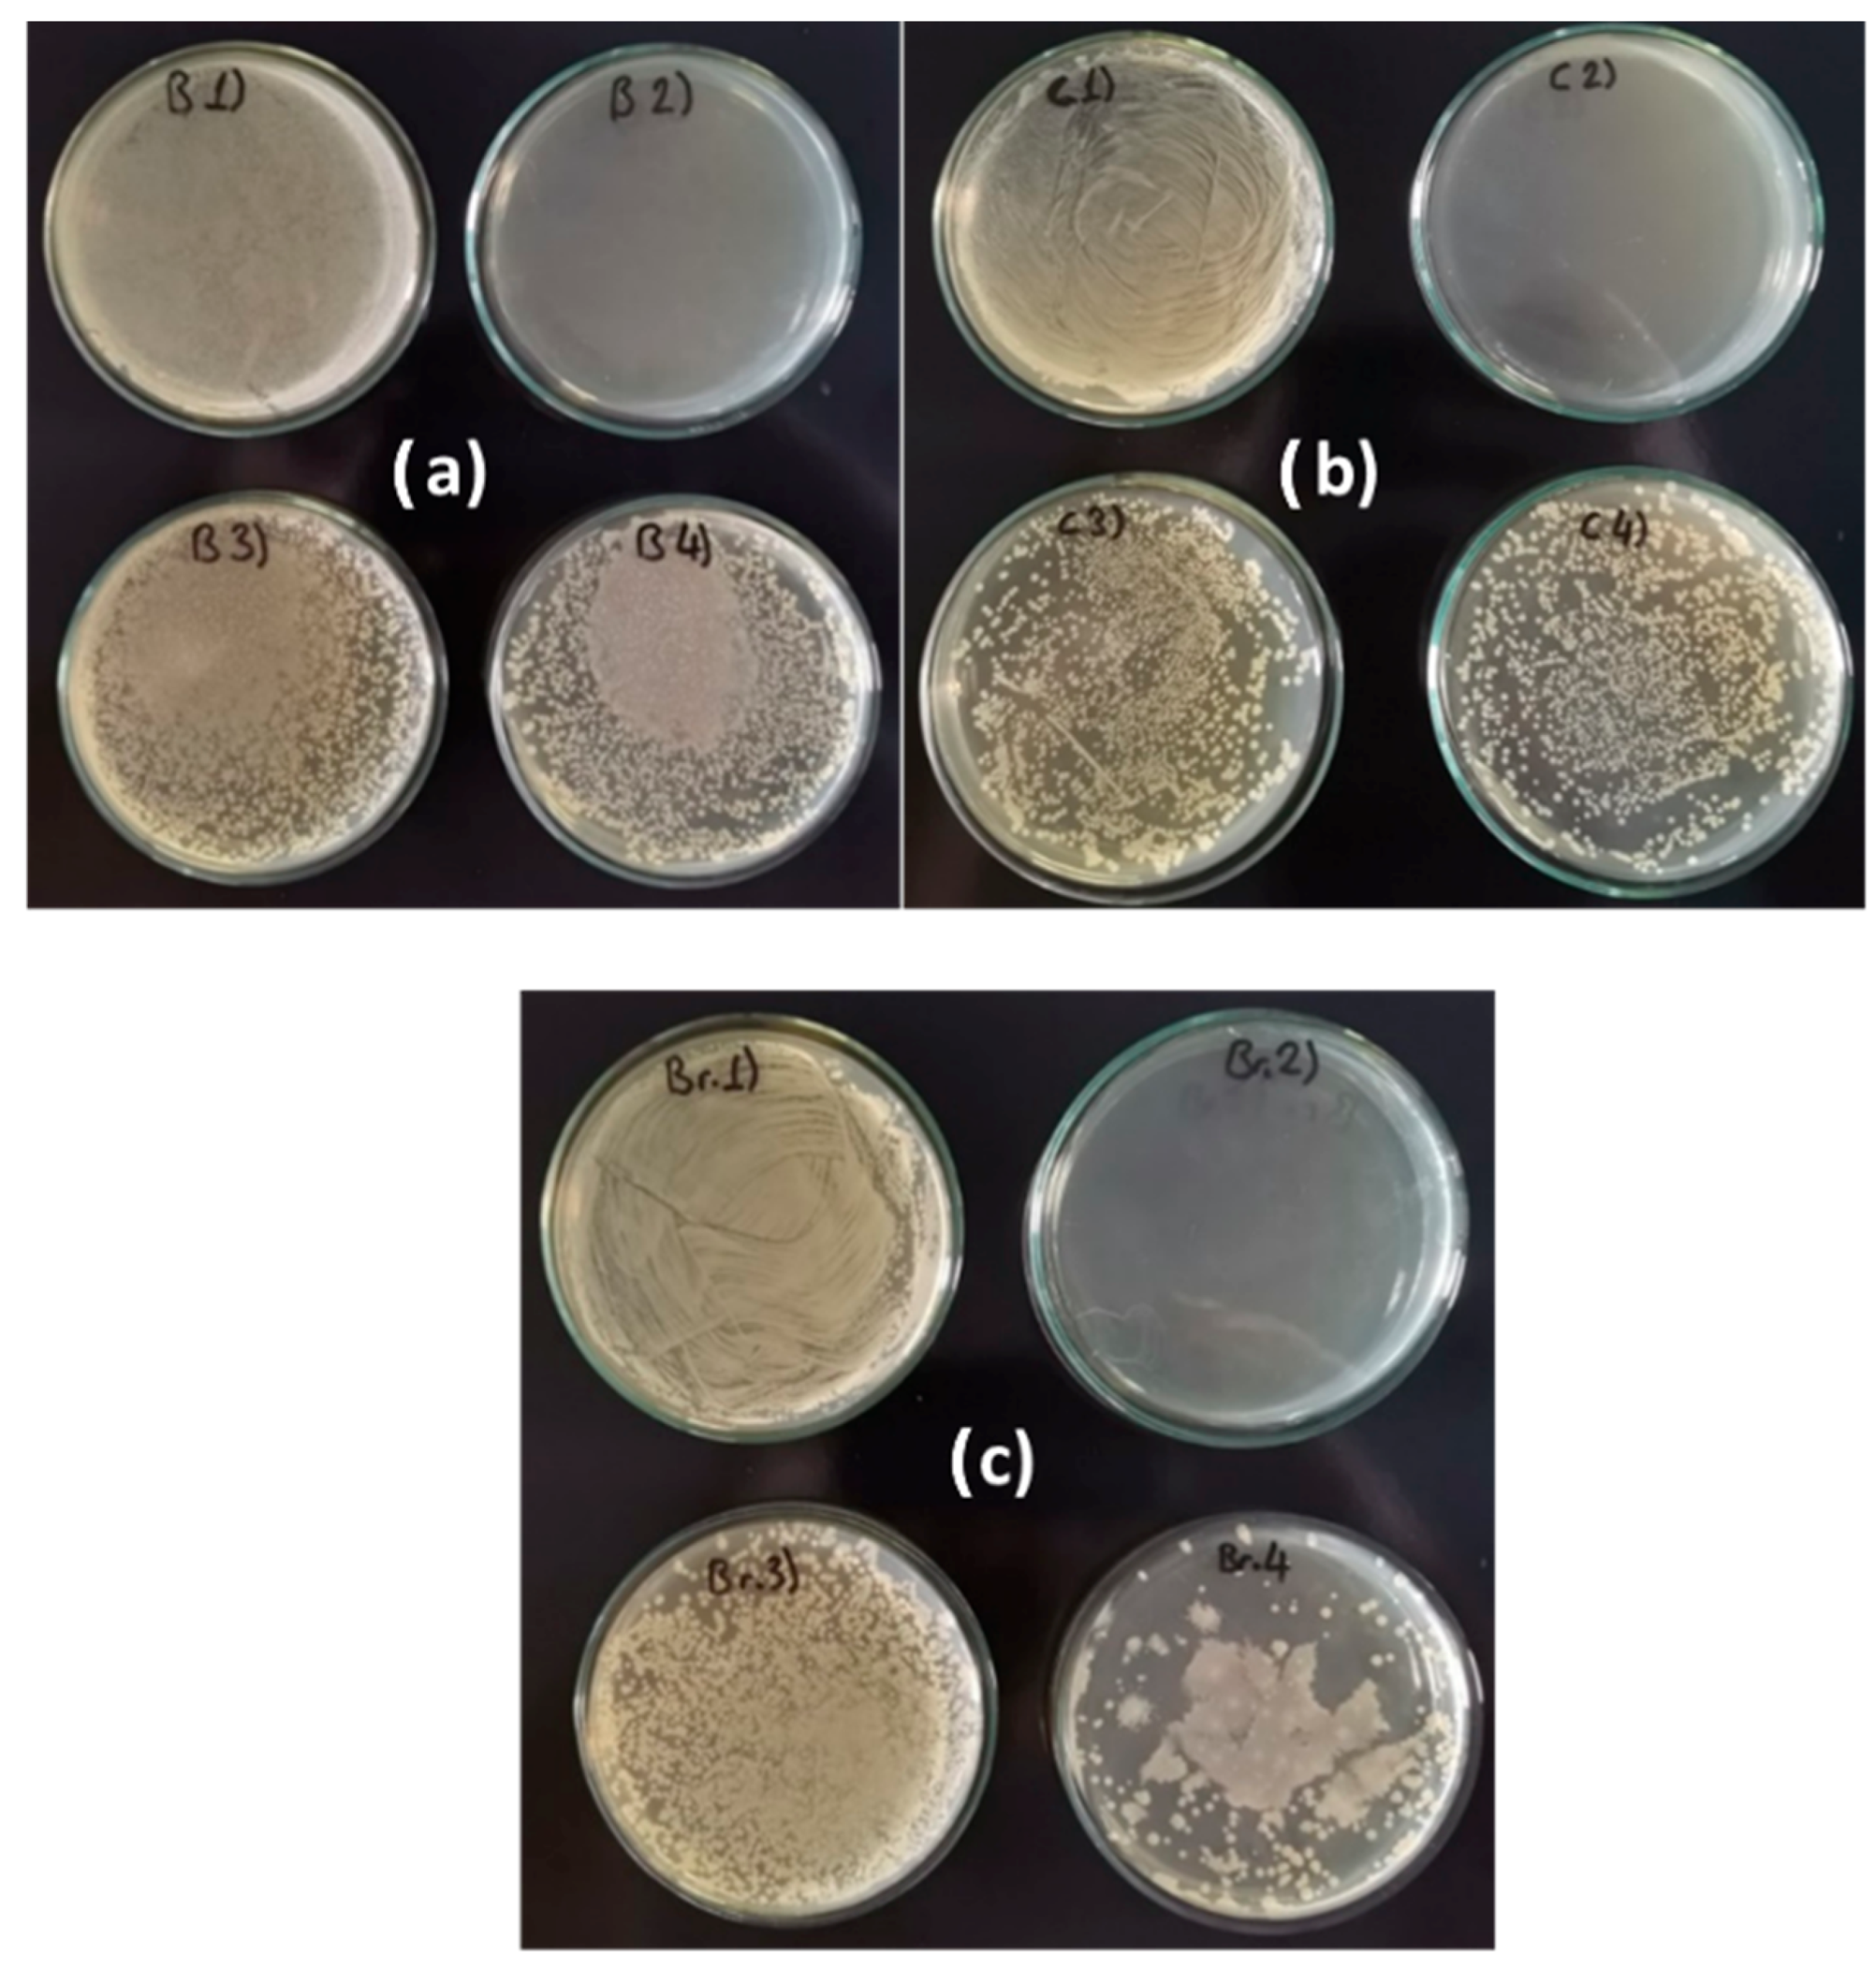

The Potential of Aloe vera and Opuntia ficus-indica Extracts as Biobased Agents for the Conservation of Cultural Heritage Metals
Abstract
1. Introduction
2. Methods
2.1. P. aeruginosa
2.2. The Plant Extracts
2.3. Metal Samples
2.4. Antibiotic
2.5. Antibacterial Experiments
2.6. Antibiofilm Experiments
2.7. Evaluation and Cleaning of Metal Samples
3. Results
3.1. Bioactive Metabolites Having a Potential Role in Biocorrosion Inhibition
3.2. Minimal Inhibitory Concentration (MIC)
3.3. Time-Kill Test
3.4. Antibiofilm Performance
3.4.1. Prevention of Biofilm Formation
3.4.2. Elimination of Formed Biofilm
3.4.3. Surface Alterations and Residue Removal After Treatment
4. Discussion
5. Conclusions
- •
- P. aeruginosa is capable of forming biofilms on copper, bronze, and brass surfaces, contributing to microbial-induced corrosion.
- •
- Both A. vera and O. ficus-indica extracts exhibited significant antibacterial activity, with a minimum inhibitory concentration of 8.3% (v/v).
- •
- A. vera demonstrated stronger bactericidal effects than O. ficus-indica, achieving ≥3 log10 reductions in bacterial counts at lower concentrations and shorter exposure times.
- •
- Both extracts effectively prevented biofilm formation and reduced established biofilms on metal surfaces.
- •
- The treatments were largely reversible, with minimal surface alteration after gentle cleaning.
Author Contributions
Funding
Institutional Review Board Statement
Informed Consent Statement
Data Availability Statement
Acknowledgments
Conflicts of Interest
References
- Del Junco, A.S.; Moreno, D.A.; Ranninger, C.; Ortega-Calvo, J.J.; Sáiz-Jiménez, C. Microbial induced corrosion of metallic antiquities and works of art: A critical review. Inter. Biodeter. Biodegr. 1992, 29, 367–375. [Google Scholar] [CrossRef]
- Yuk, S.; Azam, A.H.; Miyanaga, K.; Tanji, Y. The contribution of nitrate-reducing bacterium Marinobacter YB03 to biological souring and microbiologically influenced corrosion of carbon steel. Biochem. Eng. J. 2020, 156, 107520. [Google Scholar] [CrossRef]
- Liu, B.; Li, Z.; Yang, X.; Du, C.; Li, X. Microbiologically influenced corrosion of X80 pipeline steel by nitrate reducing bacteria in artificial Beijing soil. Bioelectrochemistry 2020, 135, 107551. [Google Scholar] [CrossRef]
- Li, H.; Sun, M.; Du, M.; Zheng, Z.; Ma, L. Mechanism underlying the acceleration of pitting corrosion of B30 copper–nickel alloy by Pseudomonas aeruginosa. Front. Microbiol. 2023, 14, 1149110. [Google Scholar] [CrossRef]
- Li, X.L.; L Narenkumar, J.; Rajasekar, A.; Ting, Y.P. Biocorrosion of mild steel and copper used in cooling tower water and its control. 3 Biotech 2018, 8, 178. [Google Scholar] [CrossRef]
- Dou, W.; Pu, Y.; Gu, T.; Chen, S.; Chen, Z.; Xu, Z. Biocorrosion of copper by nitrate-reducing Pseudomonas aeruginosa with varied headspace volume. Inter. Biodeter. Biodegr. 2022, 171, 105405. [Google Scholar] [CrossRef]
- Mates, A. The significance of testing for Pseudomonas aeruginosa in recreational seawater beaches. Microbios. 1992, 71, 89–93. [Google Scholar] [PubMed]
- Amendola, R.; Acharjee, A. Microbiologically influenced corrosion of copper and its alloys in anaerobic aqueous environments: A review. Front. Microbiol. 2022, 13, 806688. [Google Scholar] [CrossRef]
- Benzidia, B.; Barbouchi, M.; Rehioui, M.; Hammouch, H.; Erramli, H.; Hajjaji, N. Aloe vera mucilage as an eco-friendly corrosion inhibitor for bronze in chloride media: Combining experimental and theoretical research. J. King Saud Univ. Sci. 2023, 35, 102986. [Google Scholar] [CrossRef]
- Abiola, O.K.; James, A.O. The effects of Aloe vera extract on corrosion and kinetics of corrosion process of zinc in HCl solution. Corros. Sci. 2010, 52, 661–664. [Google Scholar] [CrossRef]
- González-Parra, J.R.; Di Turo, F. Using Plant Extracts as Sustainable Corrosion Inhibitors for Cultural Heritage Alloys: A Mini-Review. Sustainability 2024, 16, 1868. [Google Scholar] [CrossRef]
- Mahmoud, G.A.; Abdel-karim, A.M.; Saleh, S.M.; El-Meligi, A.A.; El-Rashedy, A.A. Corrosion inhibition of copper alloy of archaeological artifacts in chloride salt solution using Aloe vera green inhibitor. J. Alloys Compd. 2025, 1010, 177540. [Google Scholar] [CrossRef]
- Torres-Acosta, A.A.; González-Calderón, P.Y. Opuntia ficus-indica (OFI) Mucilage as Corrosion Inhibitor of Steel in CO2-Contaminated Mortar. Materials 2021, 14, 1316. [Google Scholar] [CrossRef]
- Argyropoulos, V.; Boyatzis, S.C.; Giannoulaki, M.; Guilminot, E.; Zacharopoulou, A. Organic Green Corrosion Inhibitors Derived from Natural and/or Biological Sources for Conservation of Metals Cultural Heritage. In Microorganisms in the Deterioration and Preservation of Cultural Heritage; Joseph, E., Ed.; Springer: Cham, Switzerland, 2021. [Google Scholar] [CrossRef]
- Dong-Myong, K.; Ju-Yeong, J.; Hyung-Kon, L.; Yong-Seong, K.; Yeon-Mea, C. Determination and Profiling of Secondary Metabolites in Aloe vera, Aloe Arborescens and Aloe Saponaria. Biomed. J. Sci. Tech. Res. 2021, 40, 32555–32563. [Google Scholar] [CrossRef]
- Chandel, N.S.; Singh, H.B.; Vaishnav, A. Mechanistic understanding of metabolic cross-talk between Aloe vera and native soil bacteria for growth promotion and secondary metabolites accumulation. Front. Plant Sci. 2025, 16, 1577521. [Google Scholar] [CrossRef]
- Agwa, O.K.; Iyalla, D.; Abu, G.O. Inhibition of bio-corrosion of steel coupon by sulphate reducing bacteria and iron oxidizing bacteria using Aloe vera (Aloe barbadensis) extracts. J. Appl. Sci. Environ. Manag. 2017, 21, 833–838. [Google Scholar] [CrossRef]
- Abdel-Karim, A.M.; El-Shamy, A.M. A Review on Green Corrosion Inhibitors for Protection of Archeological Metal Artifacts. J. Bio. Tribo Corros. 2022, 8, 35. [Google Scholar] [CrossRef]
- Camarena-Rangel, N.G.; Barba-De la Rosa, A.P.; Herrera-Corredor, J.A.; Santos-Díaz, M.D.S. Enhanced production of metabolites by elicitation in Opuntia ficus-indica, Opuntia megacantha, and Opuntia streptacantha callus. Plant Cell Tiss. Organ Cult. 2017, 129, 289–298. [Google Scholar] [CrossRef]
- Scognamiglio, F.; Mirabile Gattia, D.; Roselli, G.; Persia, F.; De Angelis, U.; Santulli, C. Thermoplastic starch films added with dry nopal (Opuntia ficus-indica) fibers. Fibers 2019, 7, 99. [Google Scholar] [CrossRef]
- Emanuele, L.; Dujaković, T.; Roselli, G.; Campanelli, S.; Bellesi, G. The Use of a Natural Polysaccharide as a Solidifying Agent and Color-Fixing Agent on Modern Paper and Historical Materials. Organics 2023, 4, 265–276. [Google Scholar] [CrossRef]
- Mokrani, S.; Ibrahim, N.A.; Benaricha, B.; Houali, K.; Cruz, C.; Boungab, K.; Bousedra, F.; Bensekrane, Z.; Aleissa, M.S.; Basher, N.S.; et al. Phytochemical Characterization and Antifungal Potential of Opuntia ficus-indica Cladode Extracts Against Tomato Pathogens. Processes 2025, 13, 1412. [Google Scholar] [CrossRef]
- Matos Acurero, A. Aloesin, aloin and aloe-emodin production in Aloe vera L. calli. Ciencia 2008, 16, 382–395. [Google Scholar]
- Dong-Myong, K.; Ju-Yeong, J.; Hyung-Kon, L.; Yong-Seong, K.; Yeon-Mea, C. Determination and Profiling of Secondary Metabolites in Aloe Vera, Aloe Arborescens and Aloe Saponaria. Adv. Bioeng. Biomed. Sci. Res. 2021, 4, 129–136. [Google Scholar]
- Shinyuy, L.M.; Loe, G.E.; Jansen, O.; Mamede, L.; Ledoux, A.; Noukimi, S.F.; Abenwie, S.N.; Ghogomu, S.M.; Souopgui, J.; Robert, A.; et al. Secondary Metabolites Isolated from Artemisia afra and Artemisia annua and Their Anti-Malarial, Anti-Inflammatory and Immunomodulating Properties—Pharmacokinetics and Pharmacodynamics: A Review. Metabolites 2023, 13, 613. [Google Scholar] [CrossRef] [PubMed]
- Machado-Carvalho, L.; Martins, T.; Aires, A.; Marques, G. Optimization of Phenolic Compounds Extraction and Antioxidant Activity from Inonotus hispidus Using Ultrasound-Assisted Extraction Technology. Metabolites 2023, 13, 524. [Google Scholar] [CrossRef]
- Özdemir, Ç.; Erol, A.; Scrano, L. Comparative examination of in vitro methods to evaluate the antimicrobial activity of biomaterials. Emergent Mater. 2024, 7, 2605–2621. [Google Scholar] [CrossRef]
- Li, F.; Weir, M.D.; Fouad, A.F.; Xu, H.H. Time-kill behaviour against eight bacterial species and cytotoxicity of antibacterial monomers. J. Dent. 2013, 41, 881–891. [Google Scholar] [CrossRef]
- Chukwuma, O.B.; Rafatullah, M.; Tajarudin, H.A.; Ismail, N. Bacterial Diversity and Community Structure of a Municipal Solid Waste Landfill: A Source of Lignocellulolytic Potential. Life 2021, 11, 493. [Google Scholar] [CrossRef]
- Tharek, M.; Mat Amin, N. Bacterial community structure of fresh and composted cattle manure revealed through 16S rRNA gene amplicon sequencing. Microbiol Resour. Announc. 2025, 14, e01092-24. [Google Scholar] [CrossRef]
- Petersen, P.J.; Jones, C.H.; Bradford, P.A. In vitro antibacterial activities of tigecycline and comparative agents by time-kill kinetic studies in fresh Mueller-Hinton broth. Diagn. Micr. Infec. Dis. 2007, 59, 347–349. [Google Scholar] [CrossRef]
- Sim, J.H.; Jamaludin, N.S.; Khoo, C.H.; Cheah, Y.K.; Halim, S.N.B.A.; Seng, H.L.; Tiekink, E.R. In vitro antibacterial and time-kill evaluation of phosphanegold (I) dithiocarbamates, R 3 PAu [S 2 CN (iPr) CH 2 CH 2 OH] for R= Ph, Cy and Et, against a broad range of Gram-positive and Gram-negative bacteria. Gold Bull. 2014, 47, 225–236. [Google Scholar] [CrossRef]
- Hamman, J.H. Composition and applications of Aloe vera leaf gel. Molecules 2008, 13, 1599–1616. [Google Scholar] [CrossRef] [PubMed]
- Khan, A.; Kanwal, F.; Ullah, S.; Fahad, M.; Tariq, L.; Altaf, M.T.; Riaz, A.; Zhang, G. Plant Secondary Metabolites—Central Regulators Against Abiotic and Biotic Stresses. Metabolites 2025, 15, 276. [Google Scholar] [CrossRef]
- Mesbah, M.; Douadi, T.; Sahli, F.; Issaadi, S.; Boukazoula, S.; Chafaa, S. Synthesis, characterization, spectroscopic studies and antimicrobial activity of three new Schiff bases derived from Heterocyclic moiety. J. Mol. Struct. 2018, 1151, 41–48. [Google Scholar] [CrossRef]
- Ennouri, M.; Ammar, I.; Khemakhem, B.; Attia, H. Chemical composition and antibacterial activity of Opuntia ficus-indica F. Inermis (Opuntia ficus-indica Pear) Flowers. J. Med. Food 2014, 17, 908–914. [Google Scholar] [CrossRef]
- Arbab, S.; Ullah, H.; Weiwei, W.; Wei, X.; Ahmad, S.U.; Wu, L.; Zhang, J. Comparative study of antimicrobial action of Aloe vera and antibiotics against different bacterial isolates from skin infection. Vet. Med. Sci. 2021, 7, 2061–2067. [Google Scholar] [CrossRef]
- Leitgeb, M.; Kupnik, K.; Knez, Ž.; Primožič, M. Enzymatic and Antimicrobial Activity of Biologically Active Samples from Aloe arborescens and Aloe barbadensis. Biology 2021, 10, 765. [Google Scholar] [CrossRef] [PubMed]
- Alqurashi, A.S.; Al Masoudi, L.M.; Hamdi, H.; Abu Zaid, A. Chemical Composition and Antioxidant, Antiviral, Antifungal, Antibacterial and Anticancer Potentials of Opuntia ficus indica Seed Oil. Molecules 2022, 27, 5453. [Google Scholar] [CrossRef]
- Salah, I.; Parkin, I.P.; Allan, E. Copper as an antimicrobial agent: Recent advances. RSC Adv. 2021, 11, 18179–18186. [Google Scholar] [CrossRef] [PubMed] [PubMed Central]
- Wang, Y.G.; LI, H.Y.; Yuan, X.Y.; Jiang, Y.B.; Xiao, Z.A.; Zhou, L. Review of copper and copper alloys as immune and antibacterial element. Trans. Nonferrous Met. Soc. China 2022, 32, 3163–3181. [Google Scholar] [CrossRef]
- Xu, D.; Gu, T.; Lovley, D.R. Microbially mediated metal corrosion. Nat. Rev. Microbiol. 2023, 21, 705–718. [Google Scholar] [CrossRef] [PubMed]
- Dang, Y.T.; Power, A.; Cozzolino, D.; Dinh, K.B.; Ha, B.S.; Kolobaric, A.; Vongsvivut, J.; Truong, V.K.; Chapman, J. Analytical characterisation of material corrosion by biofilms. J. Bio-Tribo-Corros. 2022, 8, 50. [Google Scholar] [CrossRef]
- Pal, M.K.; Lavanya, M. Microbial influenced corrosion: Understanding bioadhesion and biofilm formation. J. Bio-Tribo-Corros. 2022, 8, 76. [Google Scholar] [CrossRef]
- Emanuele, L.; Kotlar, M.; Novalija, J.M.; Scrano, L.; Kurajica, S. Testing the green corrosion inhibitors prickly pear and aloe vera on an archeological iron sample. Int. J. Conserv. Sci. 2025. submitted. [Google Scholar]

| Metal | Composition of Treatment Solutions | |||
|---|---|---|---|---|
| P. aeruginosa | P. aeruginosa + Azithromycin | P. aeruginosa + O. ficus-indica | P. aeruginosa + A. vera | |
| Brass | B1 | B2 | B3 | B4 |
| Copper | C1 | C2 | C3 | C4 |
| Bronze | Br1 | Br2 | Br3 | Br4 |
| Compound | Concentration Range (w/w) | Our Sample (Crude Gel) (w/w) | Notes |
|---|---|---|---|
| Aloin | 0.1–0.66% in fresh leaves [23] | 0.05% | Anthraquinone with known antibacterial and antifungal activity. |
| Aloe-emodin | 0.01–0.1% in fresh leaves [23] | 0.02% | Oxidative derivative of aloin; disrupts microbial membranes. |
| Phenolic compounds | 0.02–0.2% total phenolics [24] | 0.03% | Includes flavonoids and phenolic acids; antioxidant and antimicrobial. |
| Saponins | 0.1–0.3% in gel [24] | 0.05% | Surface-active agents that disrupt biofilms. |
| Carotenoids | Trace to 0.05% (e.g., β-carotene, zeaxanthin) [24] | 0.01% | Antioxidant role: may stabilize metal surfaces. |
| Compound | Concentration Means | Our Sample (Crude Gel) | Notes |
|---|---|---|---|
| Total polyphenols | 86.6 mg GAE/100 g FW [22] | 74 mg GAE/100 g | Includes hydroxybenzoic and caffeic acids. |
| Flavonoids | 13.4 mg QE/100 g FW [22] | 24 mg QE/100 g | Includes quercetin and isorhamnetin derivatives. |
| Condensed tannins | 8.9 mg TAE/100 g FW [22] | 5 mg TAE/100 g | Astringent; can bind to bacterial proteins and enzymes. |
| Carotenoids | 0.9 mg β-CE/100 g FW [22] | 12 mg β-CE/100 g | Antioxidant: minor role in biofilm inhibition. |
Disclaimer/Publisher’s Note: The statements, opinions and data contained in all publications are solely those of the individual author(s) and contributor(s) and not of MDPI and/or the editor(s). MDPI and/or the editor(s) disclaim responsibility for any injury to people or property resulting from any ideas, methods, instructions or products referred to in the content. |
© 2025 by the authors. Licensee MDPI, Basel, Switzerland. This article is an open access article distributed under the terms and conditions of the Creative Commons Attribution (CC BY) license (https://creativecommons.org/licenses/by/4.0/).
Share and Cite
Özdemir, Ç.; Emanuele, L.; Kotlar, M.; Brailo Šćepanović, M.; Scrano, L.; Bufo, S.A. The Potential of Aloe vera and Opuntia ficus-indica Extracts as Biobased Agents for the Conservation of Cultural Heritage Metals. Metabolites 2025, 15, 386. https://doi.org/10.3390/metabo15060386
Özdemir Ç, Emanuele L, Kotlar M, Brailo Šćepanović M, Scrano L, Bufo SA. The Potential of Aloe vera and Opuntia ficus-indica Extracts as Biobased Agents for the Conservation of Cultural Heritage Metals. Metabolites. 2025; 15(6):386. https://doi.org/10.3390/metabo15060386
Chicago/Turabian StyleÖzdemir, Çağdaş, Lucia Emanuele, Marta Kotlar, Marina Brailo Šćepanović, Laura Scrano, and Sabino Aurelio Bufo. 2025. "The Potential of Aloe vera and Opuntia ficus-indica Extracts as Biobased Agents for the Conservation of Cultural Heritage Metals" Metabolites 15, no. 6: 386. https://doi.org/10.3390/metabo15060386
APA StyleÖzdemir, Ç., Emanuele, L., Kotlar, M., Brailo Šćepanović, M., Scrano, L., & Bufo, S. A. (2025). The Potential of Aloe vera and Opuntia ficus-indica Extracts as Biobased Agents for the Conservation of Cultural Heritage Metals. Metabolites, 15(6), 386. https://doi.org/10.3390/metabo15060386

